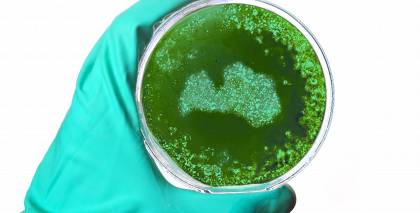

PIETURZĪMES:
Dr.habil.med. LUDMILA VĪKSNA
* Profesore Rīgas Stradiņa universitātē, Infektoloģijas katedras vadītāja.
* Rīgas Austrumu klīniskās universitātes slimnīcas infektoloģijas galvenā speciāliste.
* Infektoloģe ar 40 gadu pieredzi, autore vairākām grāmatām par infekciju slimībām.
* Strādājusi par pasniedzēju arī universitātēs Ķīnā un Vjetnamā.
* Triju Zvaigžņu ordeņa virsniece, saņēmusi balvu Glāsts 2019 par mūža ieguldījumu HIV infekcijas mazināšanā Latvijā.
* Pati ir potēta pret gripu, pneimokoku infekciju, A un B hepatītu, dzelteno drudzi, ērču encefalītu u. c.
* Vīrusu sezonā vairāk ēd augļus (piemēram, granātābolus), svaigus dārzeņus, valriekstus, diedzētus asnus.
No vienas puses, mums saka: koronavīruss ir vienkārši akūti respiratora slimība, būtībā nieka lieta. No otras puses – pēc slimniekiem dezinficē lidmašīnas kā pēc mēra, slēdz noteiktas teritorijas, iestādes, skolas, kaimiņi lietuvieši pat piesaistījuši armijas spēkus. Cilvēkos tas rada trauksmi. Kāpēc viss ir tik pretrunīgi?
Jā, pretrunas ir, jo ir daudz nezināmā. Tas satrauc ne tikai tautu, bet arī epidemiologus un citus ārstus. Šo to par vīrusu mēs jau zinām, un te jāsaka paldies Ķīnas kolēģiem, kuri visu laiku informē pasauli. Tomēr nezināmā ir ļoti daudz. Nav skaidrs, kāda būs mirušo statistika – šis procents pa valstīm ļoti atšķiras, un to, iespējams, varēs saprast tikai tad, kad epidēmija būs vai nu beigusies, vai vismaz nopietni mazinājusies. Tāpat precīzi nezinām, cik dienu pirms simptomu parādīšanās vīruss jau var būt lipīgs.
Nezinām arī par šīm 14 dienām, ko cilvēki lūgti palikt mājās, – vai tas ir pietiekami ilgi?
Varbūt vajag vairāk, bet varbūt mazāk? Tāpat arī nav īstas skaidrības par pārneses ceļiem. Skaidrs, ka galvenais ir gaisa pilienu ceļš, bet, iespējams, ir vēl citi. Piemēram, ir izskanējusi informācija par fekāli orālo ceļu. Vēl ir arī kontaktu ceļš, kad cilvēks pieskaras beigtam dzīvniekam un tad ar rokām aiztiek savu muti, seju. Starp citu – cilvēks liek roku pie sejas vismaz 15 reižu stundā.
Tiem, kas pieņem lēmumus, jāņem vērā Pasaules Veselības organizācijas rekomendācijas. Kāpēc tomēr ir vērojama arī tāda histēriska reakcija?
Es tomēr nelietotu vārdu histēriska. Katrai valdībai ir savs pamatojums rīcībai. Piemēram, Itālija palaida garām to pirmo brīdi, un, kad saprata, jau bija diezgan daudz saslimušo, arī mirušo skaits ir lielāks. Ķīnā, Uhaņā, viss pamazām stabilizējas, jo viņi pieņēma acumirklīgus lēmumus, un tam arī bija fantastiskas iespējas. Tur uzceltas trīs īpašās slimnīcas, visu vajadzīgo pa slimnīcām izvadā roboti. Tāpēc tie skaļie lēmumi ir pietiekami pamatoti. Par kaimiņiem lietuviešiem un armiju – lietuviešu kolēģis teica: tas bijis valdības lēmums, bijuši sabijušies, vēlāk varēsim uzzināt, vai šādam lēmumam bija pamats. Turklāt man liekas – pašlaik labāk ir pārspīlēt, nevis otrādi, jo varu iedomāties, ko jūs, žurnālisti, mums teiktu, ja pēkšņi Latvijā slimība strauji izplatītos: re, kā lietuviešiem ir, re, kā ķīniešiem ir, bet kāpēc mums nav? Latvijai bija laiks sagatavoties, visi dienesti ir formā. Un tas, ka mēs nodrošinām paraugu ņemšanu reģionos un pie cilvēkiem mājās – tas ir labs un pamatots lēmums!
Šobrīd zināms, ka īpašā riska grupa ir cilvēki gados un vīrieši. Kāpēc tā?
Mirstības rādītāji uzrāda mazliet lielāku vīriešu skaitu – to pagaidām grūti izskaidrot. Piemēram, Ķīnā tas varētu būt saistīts ar arodfaktoriem – vīrieši biežāk strādā tirgū un līdzīgās vietās. Šī slimība vispār ir bīstamāka cilvēkiem gados, jo elpošanas sistēma jau ir fizioloģiski izmainījusies, viss kļuvis mazāk funkcionāls. Jaunam cilvēkam alveolas ir elastīgas, krūšu kurvis skaisti elpo, visi muskuļi pilnvērtīgi piedalās, bet veciem zūd elastība, muskuļu masa un daudz kas cits. Te mans ieteikums – noteikti ir vērts vakcinēties ar pneimokoku vakcīnu. Mūsos ir baktērijas, un, kad cilvēks ir novājināts, piemēram, ar gripu vai koronavīrusu, tad aktivizējas baktērijas un rodas komplikācijas, kas parasti ir nāves iemesls. No tā var izvairīties.
Kāpēc vienam vīruss izpaužas kā viegla saaukstēšanās, ko var pat vispār nepamanīt, bet citam noris smagi?
To nosaka vairāki faktori – cilvēka iedzimtā imunitāte, vīrusa īpašības un daudzums, kā arī organisma atbildes reakcija, veidojot specifiskās antivielas pret konkrētu vīrusu. Ja organismā nonāk daudz vīrusa – tas var ierosināt nopietnāku patoloģiju. Savukārt cilvēka imūnā sistēma ir visai sarežģīta padarīšana – tiklīdz patogēns, piemēram, koronavīruss, iekļūst organismā, mobilizējas nespecifiskā imunitāte. Tā ir pirmā, kas mēģina izveidot barjeru. Ja cilvēks ir gana vesels, tad ar šo arī viss apstājas. Ja pirmā barjera ir ar defektiem, ieslēdzas nākamais nespecifiskās imunitātes līmenis, organisms joprojām mēģina cīnīties, un ļoti bieži šī cīņa beidzas ar organisma uzvaru. Pa to laiku ir jāveidojas specifiskajai imunitātei – antivielām pret konkrēto ierosinātāju. Pēc tam šīs antivielas pasargās mūs, ja tas pats vīruss mēģinās iekļūt organismā vēlreiz. Ir daudz lielāka garantija, ka otrreiz vairs nesaslimsim. Bet otrreiz tomēr var saslimt, ja organismā iekļuvušais vīruss būtiski atšķiras no iepriekšējā un specifiskās antivielas to neatpazīst vai antivielu veidošanās nav pilnvērtīga.
Tātad – jāstiprina imunitāte?
Jā, bet nekādā gadījumā tagad nevajadzētu uz savu galvu sākt lietot kaut kādus imunitātes stiprinātājus. Katrā ziņā nekas no aptieku bezrecepšu piedāvājuma nederēs. Ja cilvēkam liekas, ka ar imunitāti kaut kas nav kārtībā, bieži slimo, ir vārgums, nav enerģijas – vajadzīga diagnostika pie ārsta, piemēram, imunologa. Ir jānoskaidro, kāpēc tā un kas notiek organismā. Bieži izrādās, ka cilvēkam ir kāda konkrēta iepriekš nediagnosticēta slimība. Bet, ja cilvēkam nespecifiskā imūnā sistēma sargā savu teritoriju – spēj mobilizēties, lai tiktu vaļā no vīrusa vai cita patogēna, – lielākoties tas arī izdodas, un cilvēks nemaz neuzzina, ka ir bijis apdraudēts. Ja vīruss pārvar šo imūnās sistēmas barjeru, ieslēdzas aizsardzības nākamais līmenis, kurā imūnajām šūnām ir stingra darba vai uzdevumu dalīšana – kā pie skudrām. Ja arī tas nelīdz un specifiskā imunitāte un antivielas neizveidojas, cilvēks saslimst. Specifiskās imunitātes veidošanai izmanto vakcīnas.
Un kā te var kaitēt imūnstiprinātāji?
Ja cilvēks, būdams praktiski vesels, uz savu galvu ir lietojis imūnsistēmas stimulatorus, organisma paša imūnās sistēmas atslābst, jo vairs nav jāsaspringst. Ja notiek inficēšanās ar kādu patogēnu, organisms pienācīgi ar saviem spēkiem nereaģē un kļūst kā tāds bezdarbnieks, kas tikai gaida bezdarbnieka pabalstu. Tas ir līdzīgi kā braucot ar mašīnu – nevaram taču visu laiku tikai gāzēt un gāzēt, jo tad mašīna būs pagalam. Arī vitamīni nav vielas, ko var lietot, kā ienāk prātā. Tāpat no bieži lietojamu zāļu, piemēram, paracetamola, pārdozēšanas var nomirt. Jābūt uzmanīgiem.
Vācijas presē citēta kāda turienes virusoloģijas autoritāte, kas uzsver: jauno koronavīrusu dabūs līdz 70 procentiem valsts iedzīvotāju, visdrīzāk – divu gadu laikā. Vai jums ir kāda prognoze Latvijai?
Jā, varu šai prognozei piekrist, pie mums varētu būt līdzīgi. Es gan nelietotu vārdu pārslimosim, bet liela daļa no mums būs bijusi kontaktā ar šo vīrusu – tik lielā mērā, lai izveidotos nepieciešamās antivielas pret aktuālo koronavīrusu.
Tātad tas ir kaut kas, kas mums vienkārši jāpieņem?
Es neesmu fatālisma teoriju piekritēja, bet mēs ikdienā sastopamies ar milzīgu daudzumu patogēnu un pat nenojaušam, kādas tik īpašas antivielas mūsu organismā jau nav pret to, šo un vēl citu slimību. Varbūt vienīgi pret bakām mums nav antivielu, jo šī slimība cilvēkiem jau ir izskausta, bet pret visu pārējo…
Iesākumā koronavīrusu salīdzināja ar gripu. Šāds salīdzinājums joprojām ir korekts?
Izplatības veids un simptomu izpausme pilnīgi noteikti ir līdzīga, un pēc simptomiem vien ārsts nevarēs atšķirt gripu no koronavīrusa. Tāpēc mēs Latvijā, izmeklējot pacienta biomateriālu, izmeklējam ne tikai, vai ir koronavīruss. Mums ir panelis ar vēl 16 vīrusiem un, ja vajag, vēl vairāk! Un skatāmies visu, lai nav tā, ka saspringstam uz koronavīrusu un tāpēc nepamanām gripu.
Vai tomēr koronavīruss šobrīd nav bīstamāks, salīdzinot mirstības rādītājus?
Tā īsti nevar teikt. Gripai mums ir zāles un vakcīna – ja to nebūtu, nezinām, kāda tad būtu mirušo statistika, noteikti lielāka. Otrs – pie gripas esam diezgan pieraduši. Ja gripas epidēmijas laikā noteiktā teritorijā saskaita mirušos, būs par 10–30 procentiem vairāk nekā tajās teritorijās, kur gripas nav bijis. Nomirušajiem diagnozē līdztekus gripai ierakstīts – cukura diabēts, plaušu karsonis, sirds mazspēja, bet, ja nebūtu gripas, cilvēks nebūtu nomiris! Līdz ar to ir jautājums – nomira no tā vai no šitā? Tāpēc patlaban par koronavīrusu šajā kontekstā nevar vēl spriest. Piemēram, bija ziņots par vienu gados jaunu no COVID-19 mirušu vīrieti Taizemē, bet, izrādās, viņam bija vēl arī Denges drudzis.
Oficiālā statistika par saslimušajiem ir tikai aisberga redzamā daļa. Cik lieli šie skaitļi varētu būt patiesībā – reiz divi, pieci, desmit?
To mēs tiešām nezinām. Pasaules dati par lidojumiem vēsta, ka vismaz ceturtā daļa pasaules iedzīvotāju katru gadu kaut kur lido. Un tā cilvēki sev līdzi vadā visu. Visu! Man ir vaicāts – cik ātri pie mums var nokļūt gripa, kas plosās Japānā? Es atbildu: tieši tik ilgi, cik lido lidmašīna! Kā atved, tā ir. Tāpēc mums tagad tomēr jāpatur prātā sliktākais attīstības modelis. Piemēram, atlido pilna lidmašīna ar inficētajiem, par kuriem mēs nezinām, un tad pēc dažām dienām mums jau var būt simts inficēto, pēc tam – tūkstoš utt.
Visi saslimušie ir vienlīdz bīstami apkārtējiem? Arī tie, kas slimo vieglā formā?
Tas viegli slimais, kurš nezina, ka ir slims un inficēts, bet jūtas labi un skraida apkārt, ir visbīstamākais, jo no šā cilvēka neviens neizvairās. Infektoloģijā vispār uzskata, ka smagi slimais pārējiem tikpat kā nav bīstams, jo visi saprot, ka cilvēks ir slims, viņš ir izolēts, tiek ārstēts, pārējie piesargājas, viss skaidrs.
Pret jauno koronavīrusu zāļu nav. Kā vispār cilvēkus ārstē?
Jā, pret šo konkrēto ierosinātāju medikamenta mums nav. Ko tālāk? Galvenokārt ir skarti elpceļi – sākam vērot elpošanas sistēmu, nomērām skābekļa piegādi. Ja vajag, dodam papildu skābekli. Ja ir ļoti augsta temperatūra, pazeminām to. Varam dot vielas, kas uzlabo vielmaiņu, tai skaitā – plaušās. To visu kopā sauc par patoģenētisko terapiju. Tātad mēs visādi palīdzam organismam kā tādam, bet nevaram iedarboties tieši pret vīrusu.
Kā sokas darbs pie vakcīnas izstrādes?
Dzīvniekiem vakcīnas ir, bet cilvēkiem – vēl nav. Jaunajai vakcīnai ir četrpadsmit kandidātu no kādiem vienpadsmit izstrādātājiem. Es atturēšos dot optimistiskas prognozes. Vakcīnas vēl ir ne tikai jārada, bet arī jānovērtē. COVID-19 ir ļoti mainīgs, tas vairojas nekārtīgi, es teiktu – pat cūcīgi. Tāpēc uzskatu, ka vakcīnas tik drīz nebūs, varētu paiet gadi. Ir arī iespējamība, ka vīruss mutēs, proti, izmainīsies. Korona ir agresīvs vīruss – tas taču pārrāva sugu barjeru.
Izklausās pēc agresīva īrnieka…
Šajā brīdī, kad vīruss pamanījies mainīt sugu, – jā. Un te ir vieta domām par iespējamām mutācijām. Virusologiem vēl jāpēta genoma secība, lai varētu pateikt – vai cilvēkiem ir tas pats, kas sikspārņiem, pangolīniem, suņiem, kaķiem, kamieļiem, vai tā ir kāda cita mutācija.
Varbūt tomēr ir vēl kaut kas, ko varat ieteikt cilvēkiem darīt?
Protams, nekontaktējieties ar apslimušu cilvēku tuvāk par vienu diviem metriem, vēdiniet telpas, mazgājiet rokas. Vispār vīrusiem pirmā barjera iekļūšanai organismā ir deguna un mutes dobuma gļotādas. Muti mēs lielākoties turam ciet, bet deguna gļotādu, ja jāuzturas publiskā vietā, jābrauc sabiedriskajā transportā, var ieziest ar kādu ziedi. Vislabāk – ar kādu vietējo ražojumu, piemēram, virogelu vai propolisa ziedi. Tā darbosies apmēram divas stundas.
Šāda uzņemšana vīrusam varētu nepatikt?
Jā, jo tam vajag kaut kā pieķerties! Kad tas ir pieķēries, ieurbies šūnā, noģērbies un gatavs vairoties, tad tālāk vīruss darīs visu, lai iekļūtu asinsritē un limfātiskajā sistēmā, lai varētu cirkulēt pa visu organismu. Vīrusam, starp citu, nav interesanti nobeigt cilvēku līdz nāvei, jo tad tam nav, kur dzīvot. Viņš dzīvo tikai cilvēka vai dzīvnieka šūnā! Nav kā baktērija, kas var kaut kur vēl vairoties. Vīruss bioloģiskajā izpratnē ir klasisks parazīts. Liekēdis!
Vai jūs varētu pateikt satrauktiem cilvēkiem arī kaut ko nomierinošu?
Nomierināt cilvēkus var, pasakot, kas tieši ir jādara. Tāpēc es šobrīd saku: pārtikas pietiek, vietu slimnīcā pietiek! Veikalos, transportā, lidostā ir veikti papildu piesardzības pasākumi. Slimība pamazām iet uz priekšu, bet līdz ar to cilvēku, kuriem ir izveidojušās antivielas, arī būs arvien vairāk. Man te viens otrs satraukts zvanītājs ir prasījis: kāpēc nav vakcīnas? Tad es pretī vaicāju: jūs pret gripu esat potējušies? Mums Latvijā šajā sezonā no gripas ir vairāk nekā divdesmit mirušo! Un cik – no koronavīrusa? Kaut kā cilvēkiem patīk uzķerties uz kādas domas un tad par to ņemties.
Varbūt dzīve ir bijusi tāda vienmuļa, un cilvēkiem rodas sajūta – beidzot kaut kas notiek, ir kopīgais ienaidnieks?
Jā, katra infekcija rada arī zināmu šovu. Iepriekš mums prasīja, kāpēc nav vakcīnas pret Ebolas vīrusu. Un neviens, šķiet, pat nepamanīja, ka vakcīna tika radīta un saslimstība ar Ebolas vīrusu, varētu teikt, nonullējās. Tad cilvēki uztraucās par Zikas vīrusu, un arī tas drīz zaudēja aktualitāti. Katra jauna infekcija rada tādu kopīgu baiļu un sašutuma vilni, arī kopības sajūtu. Kaut gan, no otras puses, pasaules vēsturē no infekcijām ir gājuši bojā vairāk cilvēku nekā visos zināmajos karos kopā. Pēc būtības infekcijas ir tās, kas regulē planētas dzīvi. Tagad pat – kādi zaudējumi dažādām nozarēm, industrijām! Cik daudz atceltu pasākumu!
Tātad mazgājam rokas un nestresojam?
Iespēju robežās – jā. Vīruss ārējā vidē uz virsmām varot izdzīvot četras stundas. Tas ir diezgan ilgi, jo, piemēram, HIV vīruss ārpusē dzīvo vien minūtes. Vispār visi sanitārās higiēnas un ķermeņa kultūras noteikumi principā ir jāievēro. Jūs esat tagad dzirdējusi, ka saslimušo mājās liek atsevišķā istabā, bieži vēdina telpu, maina veļu trīsreiz dienā un gultasveļu divreiz dienā, vāra viņam buljonu un dod dzērveņu morsu? Ģimenē katram ir savi trauki? Kad atnāk ārsts, viņam piedāvā iespēju nomazgāt rokas. Kad es augu, tad tā tiešām bija. Un tā ir personīgā higiēna! Ja tagad kādam to atgādināsi, teiks: mums ir citi laiki, un varu darīt, kā gribu! Bet galā arī tas iespaido dažādu slimību izplatību.
Domā, ko dari!
Slimību profilakses un kontroles centra ieteikumi koronavīrusa COVID-19 profilaksei:
- ja jūties slims, paliec mājās,
- ja saslimis bērns – neved viņu uz izglītības iestādi,
- ja jūties slims, neapciemo vecākus cilvēkus un cilvēkus ar hroniskām slimībām, jo viņiem ir lielāks risks slimot smagāk,
- ievēro roku higiēnu – mazgā rokas ar ziepēm un ūdeni vai dezinficē ar dezinfekcijas līdzekli uz alkohola bāzes,
- klepojot un šķaudot, aizliec muti un degunu ar saliektu elkoni vai salveti, pēc tam nekavējoties izmet salveti un nomazgā rokas,
- izvairies no cieša kontakta un ievēro distanci – vismaz 2 metri – no cilvēkiem ar akūtas elpceļu infekcijas simptomiem,
- izvairies aiztikt ar rokām acis, degunu un muti.
*Šī intervija tapusi vēl pirms Ārkārtas stāvokļa izsludināšanas valstī.